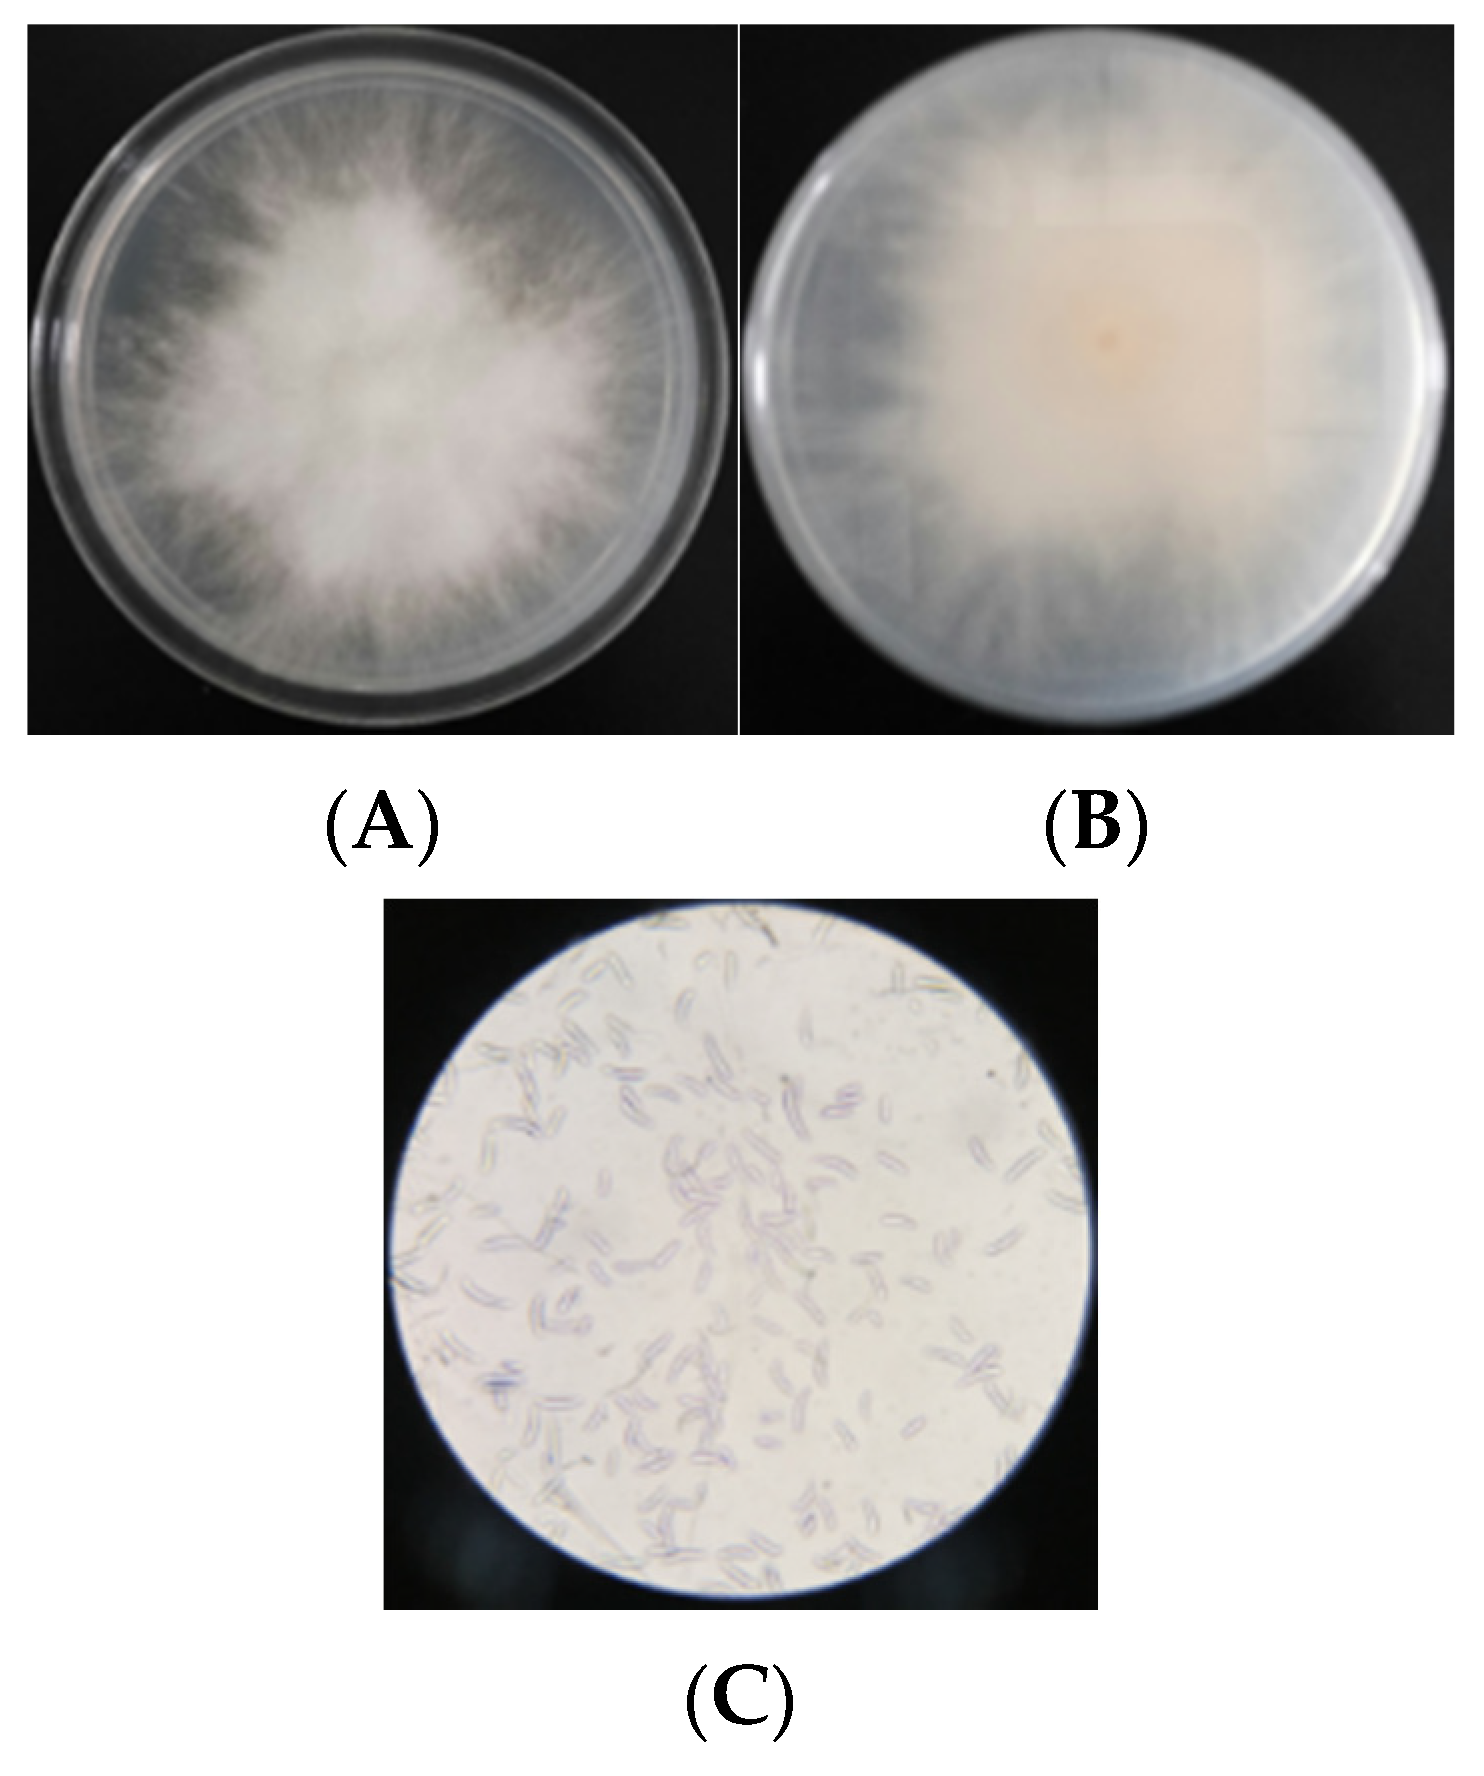
Foods 10 03051 g002

Enhancement Effect of Chitosan Coating on Inhibition of Deoxynivalenol Accumulation by Litsea cubeba Essential Oil Emulsion during Malting
Abstract
:1. Introduction
2. Materials and Methods
2.1. Materials
2.2. Apparatus
2.3. Isolation and Identification of Fusarium from Barley
2.3.1. Fusarium Isolation and ITS Identification
2.3.2. Identification of Toxins Produced by Fusarium
2.3.3. Morphological Identification
2.4. Preparation and Screening of Different Essential Oil Primary Emulsions
2.4.1. Preparation of Primary Emulsion
2.4.2. Antifungal Properties of Different Essential Oils
2.4.3. Effect of Different Primary Emulsions on Germinability of Barley
2.5. Preparation and Performance Study of Chitosan-Based Secondary Emulsion
2.5.1. Preparation of Litsea cubeba Essential Oil Secondary Emulsion
2.5.2. Study on the Physical Stability of Chitosan-Based Secondary Emulsion
2.5.3. Study on Antifungal Properties of Chitosan-Based Secondary Emulsion
2.5.4. Study on Germinability of Chitosan-Based Secondary Emulsion
2.6. Application of Secondary Emulsion in Malting
2.7. Statistical Analysis
3. Results and Discussion
3.1. Isolation and Identification of Fusarium
3.1.1. Identification of Fusarium by ITS
3.1.2. Analysis of Toxin Produced by Fusarium
3.1.3. Morphology of Fusarium F-4
3.2. Screening and Performance Analysis of Primary Emulsion
3.2.1. Inhibitory Effect of Different Essential Oils on Fusarium
3.2.2. Effect of Different Primary Emulsions on Germinability of Barley
3.3. Effect of Chitosan on the Performance of Secondary Emulsion
3.3.1. Effect of Chitosan on Physical Stability of Secondary Emulsion
3.3.2. Effect of Chitosan on Antifungal Performance of Secondary Emulsion
3.3.3. Effect of Chitosan on Germinability of Barley
3.4. Effect of Secondary Emulsion on Malting
3.4.1. Effect of Secondary Emulsion on Germination Rate and DON Accumulation
3.4.2. Effect of Secondary Emulsion on Ergosterol Accumulation during Malting
3.4.3. Effect of Secondary Emulsion Treatment on Final Malt Quality
4. Conclusions
Author Contributions
Funding
Institutional Review Board Statement
Informed Consent Statement
Data Availability Statement
Acknowledgments
Conflicts of Interest
References
- Chen, X.G.; Chu, B.B.; Gu, Q.H.; Liu, H.; Li, C.; Li, W.Z.; Lu, J.; Wu, D.H. Facile fabrication of protonated g-C3N4/oxygen-doped g-C3N4 homojunction with enhanced visible photocatalytic degradation performance of deoxynivalenol. J. Environ. Chem. Eng. 2021, 9, 106380. [Google Scholar] [CrossRef]
- Bottalico, A.; Perrone, G. Toxigenic Fusarium species and mycotoxins associated with head blight in small-grain cereals in Europe. Eur. J. Plant Pathol. 2002, 108, 611–624. [Google Scholar] [CrossRef]
- Pascari, X.; Ramos, A.J.; Marin, S.; Sanchís, V. Mycotoxins and beer. Impact of beer production process on mycotoxin contamination. A review. Food Res. Int. 2018, 103, 121–129. [Google Scholar] [CrossRef] [PubMed] [Green Version]
- Lancova, K.; Hajslova, J.; Poustka, J.; Krplova, A.; Zachariasova, M.; Dostalek, P.; Sachambula, L. Transfer of Fusarium mycotoxins and ‘masked’ deoxynivalenol (deoxynivalenol-3-glucoside) from field barley through malt to beer. Food Addit. Contam. 2008, 25, 732–744. [Google Scholar] [CrossRef] [Green Version]
- Wan, J.; Jin, Z.; Zhong, S.B.; Schwarz, P.; Chen, B.C.; Rao, J.J. Clove oil-in-water nanoemulsion: Mitigates growth of Fusarium graminearum and trichothecene mycotoxin production during the malting of Fusarium infected barley. Food Chem. 2020, 312, 126120. [Google Scholar] [CrossRef] [PubMed]
- Peng, Z.; Chen, L.K.; Nussler, A.K.; Liu, L.G.; Yang, W. Current sights for mechanisms of deoxynivalenol-induced hepatotoxicity and prospective views for future scientific research: A mini review. J. Appl. Toxicol. 2017, 37, 518–529. [Google Scholar] [CrossRef] [PubMed]
- Eriksen, G.S.; Pettersson, H. Toxicological evaluation of trichothecenes in animal feed. Anim. Feed Sci. Technol. 2004, 114, 205–239. [Google Scholar] [CrossRef]
- Temba, B.A.; Sultanbawa, Y.; Kriticos, D.J.; Fox, G.P.; Harvey, J.J.W.; Fletcher, M.T. Tools for defusing a major global food and feed safety risk: Nonbiological post-harvest procedures to decontaminate mycotoxins in foods and feeds. J. Agric. Food Chem. 2016, 64, 8959–8972. [Google Scholar] [CrossRef]
- Luo, Y.; Liu, X.J.; Li, J.K. Updating techniques on controlling mycotoxins—A review. FOOCEV 2018, 89, 123–132. [Google Scholar] [CrossRef]
- Young, J.C.; Trenholm, H.L.; Friend, D.W.; Prelusky, D.B. Detoxification of deoxynivalenol with sodium bisulfite and evaluation of the effects when pure mycotoxin or contaminated corn was treated and given to pigs. J. Agric. Food Chem. 1987, 35, 259–261. [Google Scholar] [CrossRef]
- Oneill, K.; Damoglou, A.P.; Patterson, M.F. The stability of deoxynivalenol and 3-acetyI deoxynivalenol to gamma irradiation. Food Addit. Contam. 1993, 10, 7–14. [Google Scholar] [CrossRef]
- Wang, G.; Wang, Y.X.; Ji, F.; Xu, L.M.; Yu, M.Z.; Shi, J.R.; Xu, J.H. Biodegradation of deoxynivalenol and its derivatives by Devosia insulae A16. Food Chem. 2019, 276, 436–442. [Google Scholar] [CrossRef]
- Tullio, V.; Nostro, A.; Mandras, N.; Dugo, P.; Banche, G.; Cannatelli, M.A.; Cuffini, A.M.; Alonzo, V.; Carlone, N.A. Antifungal activity of essential oils against filamentous fungi determined by broth microdilution and vapour contact methods. J. Appl. Microbiol. 2007, 102, 1544–1550. [Google Scholar] [CrossRef]
- Gill, T.A.; Li, J.; Saenger, M.; Scofield, S.R. Thymol-based submicron emulsions exhibit antifungal activity against Fusarium graminearum and inhibit Fusarium head blight in wheat. J. Appl. Microbiol. 2016, 121, 1103–1116. [Google Scholar] [CrossRef] [Green Version]
- Hyldgaard, M.; Mygind, T.; Meyer, R.L. Essential oils in food preservation: Mode of action, synergies, and interactions with food matrix components. Front. Microbiol. 2012, 3, 12. [Google Scholar] [CrossRef] [Green Version]
- Salvia-Trujillo, L.; Rojas-Graü, A.; Soliva-Fortuny, R.; Martín-Belloso, O. Physicochemical characterization and antimicrobial activity of food-grade emulsions and nanoemulsions incorporating essential oils. Food Hydrocoll. 2015, 43, 547–556. [Google Scholar] [CrossRef]
- McClements, D.J.; Rao, J. Food-grade nanoemulsions: Formulation, fabrication, properties, performance, biological fate, and potential toxicity. Crit. Rev. Food Sci. Nutr. 2011, 51, 285–330. [Google Scholar] [CrossRef]
- Donsì, F.; Annunziata, M.; Sessa, M.; Ferrari, G. Nanoencapsulation ofessential oils to enhance their antimicrobial activity in foods. J. Biotechnol. 2011, 44, 1908–1914. [Google Scholar]
- Moghimi, R.; Ghaderi, L.; Rafati, H.; Aliahmadi, A.; Mcclements, D.J. Superior Antibacterial activity of nanoemulsion of thymus daenensis essential oil against E. coli. Food Chem. 2016, 194, 410–415. [Google Scholar] [CrossRef]
- Ribes, S.; Fuentes, A.; Talens, P.; Barat, J.M.; Ferrari, G.; Donsì, F. Influence of emulsifier type on the antifungal activity of cinnamon leaf, lemon and bergamot oil nanoemulsions against Aspergillus niger. Food Control 2017, 73, 784–795. [Google Scholar] [CrossRef]
- Wu, D.H.; Lu, J.; Zhong, S.B.; Schwarz, P.; Chen, B.C.; Rao, J.J. Influence of nonionic and ionic surfactants on the antifungal and mycotoxin inhibitory efficacy of cinnamon oil nanoemulsions. Food Funct. 2019, 10, 2817–2827. [Google Scholar] [CrossRef] [PubMed]
- Khanafari, A.; Marandi, R.; Sanatei, S.H. Recovery of chitin and chitosan from shrimp waste by chemical and microbial methods. Iran. J. Environ. Health Sci. Eng. 2008, 5, 19–24. [Google Scholar]
- Limam, Z.; Selmi, S.; Sadok, S.A. El-abed Extraction and characterization of chitin and chitosan from crustacean by-products: Biological and physico-chemical propertie African. J. Biotechnol. 2011, 10, 640–647. [Google Scholar]
- Chung, Y.; Su, Y.; Chen, C.; Jia, G.; Wang, H.; Wu, J.; Lin, J.G. Relationship between antibacterial activity of chitosan and surface characteristics of cell wall. Acta Pharmacol. Sin. 2004, 25, 932–936. [Google Scholar] [PubMed]
- Ozkan, G.; Franco, P.; Iolanda, D.M.; Xiao, J.B.; Capanoglu, E. A review of microencapsulation methods for food antioxidants: Principles, advantages, drawbacks and applications. Food Chem. 2019, 272, 494–506. [Google Scholar] [CrossRef]
- Jin, Z.; Zhou, B.; Gillespie, J.; Gross, T.; Barr, J.; Simsek, S.; Brueggeman, R.; Schwarz, P. Production of deoxynivalenol (DON) and DON-3-glucoside during the malting of Fusarium infected hard red spring wheat. Food Control 2018, 85, 6–10. [Google Scholar] [CrossRef]
- Kalagatur, N.K.; Nirmal Ghosh, O.S.; Sundararaj, N.; Mudili, V. Antifungal activity of chitosan nanoparticles encapsulated with cymbopogon martinii essential oil on plant pathogenic fungi Fusarium graminearum. Front. Pharmacol. 2018, 9, 610. [Google Scholar] [CrossRef] [Green Version]
- Wu, D.H.; Wan, J.; Lu, J.; Wang, X.G.; Zhong, S.B.; Schwarz, P.; Chen, B.C.; Rao, J.J. Chitosan coatings on lecithin stabilized emulsions inhibit mycotoxin production by Fusarium pathogens. Food Control 2018, 92, 276–285. [Google Scholar] [CrossRef]
- Sun, C.; Ji, J.; Wu, S.L.; Sun, C.P.; Pi, F.W.; Zhang, Y.Z.; Tang, L.L.; Sun, X.L. Saturated aqueous ozone degradation of deoxynivalenol and its application in contaminated grains. Food Control 2016, 69, 185–190. [Google Scholar] [CrossRef]
- Pasquali, M.; Migheli, Q. Genetic approaches to chemotype determination in type B-trichothecene producing Fusaria. Int. J. Food Microbiol. 2014, 189, 164–182. [Google Scholar] [CrossRef]

| Strains | Toxin Content (mg/kg) | ||
|---|---|---|---|
| DON | 3ADON | 15ADON | |
| F-4 | 23.61 ± 0.52 | - | 215.44 ± 0.95 |
| F-7 | - | - | - |
| F-11 | - | - | - |
| Essential Oil | Diameter of Inhibition Zone (mm) | ||
|---|---|---|---|
| Fusarium solanum | Fusarium oxysporum | Fusarium graminis | |
| Blank | 0 | 0 | 0 |
| Clove oil | 35.3 ± 1.2 | 33.3 ± 1.4 | 44.9 ± 2.0 |
| Oregano oil | 29.0 ± 1.1 | 33.6 ± 1.4 | 44.2 ± 2.4 |
| Cinnamon oil | 42.2 ± 3.2 | 32.7 ± 2.3 | 58.3 ± 0.6 |
| Citronella oil | 16.1 ± 1.2 | 18.3 ± 0.6 | 20.3 ± 1.3 |
| Litsea cubeba oil | 30.6 ± 0.7 | 36.1 ± 0.9 | 30.1 ± 1.0 |
| Fennel oil | 0 | 0 | 0 |
| Patchouli oil | 0 | 0 | 0 |
| Essential Oil | Essential Oil Content (μg/L) | |||||
|---|---|---|---|---|---|---|
| Fusarium solanum | Fusarium oxysporum | Fusarium graminis | ||||
| MIC | MBC | MIC | MBC | MIC | MBC | |
| Clove oil | 500 | 1000 | 500 | 1000 | 500 | 1000 |
| Oregano oil | 1000 | 2000 | 1000 | 2000 | 1000 | 1000 |
| Cinnamon oil | 250 | 250 | 125 | 125 | 250 | 250 |
| Litsea cubeba oil | 1000 | 2000 | 500 | 500 | 2000 | 2000 |
| Citronella oil | >4000 | >4000 | >4000 | >4000 | >4000 | >4000 |
| Index | A | B | C |
|---|---|---|---|
| Moisture (%) | 4.89 ± 0.02 | 4.64 ± 0.02 | 4.81 ± 0.03 |
| Extractum (%) | 79.60 ± 0.80 | 72.20 ± 0.40 | 76.20 ± 0.50 |
| Saccharification time (min) | 10 | 20 | 10 |
| Filtering rate (min/100 mL) | 13.42 ± 1.52 | 46.75 ± 2.20 | 28.25 ± 1.25 |
| pH | 6.23 ± 0.22 | 5.93 ± 0.01 | 6.19 ± 0.05 |
| Chromaticity (EBC) | 6.13 ± 1.25 | 14.13 ± 1.02 | 7.00 ± 0.08 |
| Turbidity (EBC) | 2.36 ± 0.36 | 4.83 ± 0.75 | 3.14 ± 0.68 |
| α-amino nitrogen (mg/100 g) | 154.05 ± 1.20 | 152.16 ± 1.15 | 158.43 ± 0.04 |
| Kolbach index | 38.58 ± 1.02 | 32.73 ± 1.12 | 37.59 ± 0.52 |
Publisher’s Note: MDPI stays neutral with regard to jurisdictional claims in published maps and institutional affiliations. |
© 2021 by the authors. Licensee MDPI, Basel, Switzerland. This article is an open access article distributed under the terms and conditions of the Creative Commons Attribution (CC BY) license (https://creativecommons.org/licenses/by/4.0/).
Share and Cite
Peng, Z.; Feng, W.; Cai, G.; Wu, D.; Lu, J. Enhancement Effect of Chitosan Coating on Inhibition of Deoxynivalenol Accumulation by Litsea cubeba Essential Oil Emulsion during Malting. Foods 2021, 10, 3051. https://doi.org/10.3390/foods10123051
Peng Z, Feng W, Cai G, Wu D, Lu J. Enhancement Effect of Chitosan Coating on Inhibition of Deoxynivalenol Accumulation by Litsea cubeba Essential Oil Emulsion during Malting. Foods. 2021; 10(12):3051. https://doi.org/10.3390/foods10123051
Chicago/Turabian StylePeng, Zhengcong, Wenxu Feng, Guolin Cai, Dianhui Wu, and Jian Lu. 2021. "Enhancement Effect of Chitosan Coating on Inhibition of Deoxynivalenol Accumulation by Litsea cubeba Essential Oil Emulsion during Malting" Foods 10, no. 12: 3051. https://doi.org/10.3390/foods10123051
APA StylePeng, Z., Feng, W., Cai, G., Wu, D., & Lu, J. (2021). Enhancement Effect of Chitosan Coating on Inhibition of Deoxynivalenol Accumulation by Litsea cubeba Essential Oil Emulsion during Malting. Foods, 10(12), 3051. https://doi.org/10.3390/foods10123051
